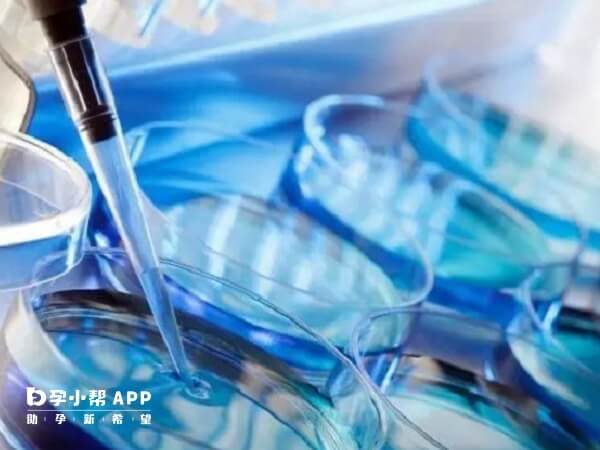
尖锐湿疹主要是人乳头瘤病毒感染引起

做试管婴儿期间,女性进行的HPV(人乳头瘤病毒)检测和TCT(宫颈液基薄层细胞技术),一般是可以间接筛查尖锐湿疹的,不过该病症若是处于潜伏期(无明显症状),或不易检测的部位(如阴道深部、肛门周围),那么也许不能筛查出病症,这也许就会损害生殖系统功能。
尖锐湿疣,又称生殖器疣,是一种性传播疾病,由人类乳头瘤病毒(HPV)感染所引起,主要表现是外生殖器及肛门周围出现整生物,也就是很多“小疙瘩"。 尖锐湿疹主要是人乳头瘤病毒感染引起,好发于肛门和外生殖器部位,多数患者没有明显的症状,部分患者可能会出现异物感、疼痛、瘙痒等症状,伴有菜花状以及鸡冠状赘生物。随着病情的发展,会导致体内病毒含量增多,造成免疫力低下,导致局部赘生物生长的速度加快。
1、母婴传播风险
若女性在孕期感染HPV,病毒可能通过产道传播给胎儿,导致新生儿出现喉乳头瘤等疾病。虽然多数婴儿可自行清除病毒,但仍存在潜在风险。
2、胚胎着床与发育
感染期间,女性免疫系统可能受影响,导致子宫内膜环境改变,影响胚胎着床成功率。若HPV引发宫颈病变(如宫颈癌前病变),可能进一步损害生殖系统功能。
试管婴儿治疗前,女方通常需进行HPV(人乳头瘤病毒)检测和TCT(宫颈液基薄层细胞技术)检查。HPV检测可判断是否感染与尖锐湿疣相关的病毒类型(如HPV6、11型),TCT检查则能观察宫颈细胞是否存在异常病变。若两项检查结果均为阴性,可基本排除尖锐湿疣及相关病变。
